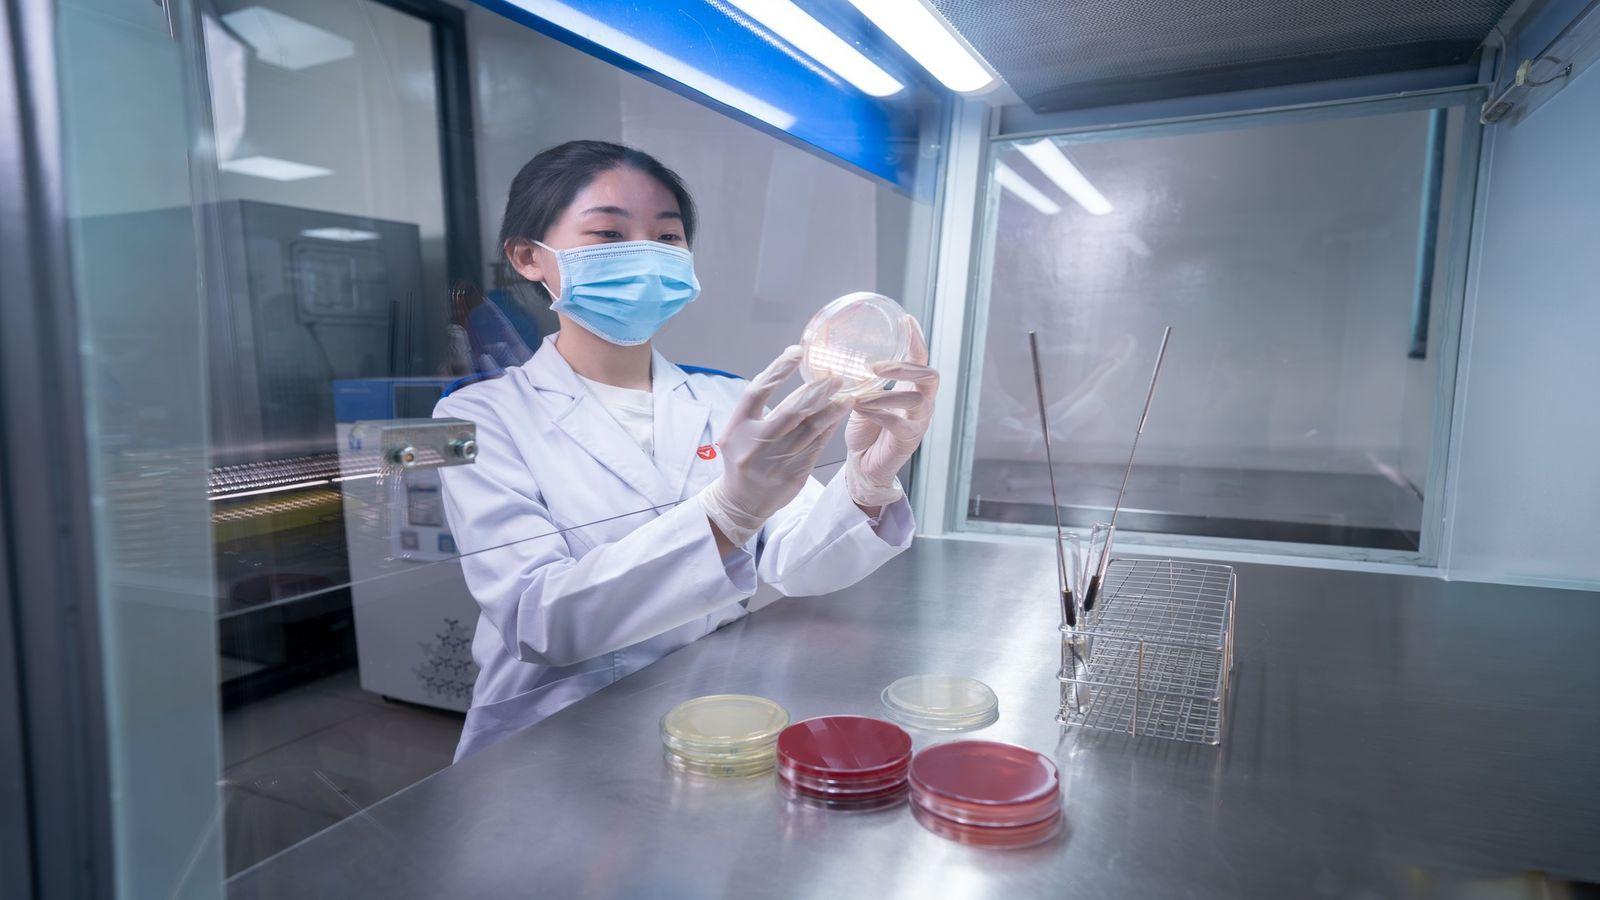
Cử nhân

Tổng quan
Ngành học có tính ứng dụng cao trong y học
Xét nghiệm y học là khâu thiết yếu trong quá trình chăm sóc và bảo vệ sức khỏe con người.
Chương trình đào tạo cung cấp các mô hình và kỹ thuật xét nghiệm y khoa hiện đại
Đáp ứng yêu cầu của hệ thống y tế hiện nay.
Sự đồng hành của đội ngũ giảng viên
Có chuyên môn sâu và kinh nghiệm thực tiễn trong lĩnh vực khoa học sức khỏe.
Chuỗi thực hành chuyên môn gắn liền với yêu cầu nghề nghiệp
Giúp người học sẵn sàng thích ứng với môi trường làm việc sau tốt nghiệp.
Learning by Doing
Học để hành nghề Sinh viên học tập thông qua ca bệnh thực tế, thực hành lâm sàng ngay từ năm nhất. Chương trình đào tạo được triển khai liên tục, không tách rời lý thuyết và thực tiễn, giúp sinh viên phát triển tư duy và sẵn sàng làm việc trong hệ thống y tế chuyên nghiệp.
Điểm nổi bật của chương trình
Chương trình đào tạo
- Sinh lý bệnh - miễn dịch
- Bệnh học nội ngoại khoa
- Dịch tễ học bệnh truyền nhiễm
- Độc chất học
- Hoá sinh, vi sinh, ký sinh trùng
- Kỹ thuật xét nghiệm cơ bản
- Điều dưỡng cơ bản - Cấp cứu ban đầu
- Kiểm soát nhiễm khuẩn trong thực hành nghề nghiệp
- Huyết học truyền máu, đông máu
- Thực hành bệnh viện
- Xét nghiệm tế bào
- Quản lý chất lượng phòng xét nghiệm
- 8 học phần Anh văn đạt chuẩn NEAS (Úc), đảm bảo chuẩn đầu ra IELTS 6.0
- Thực tập tốt nghiệp
- Khoá luận tốt nghiệp
- Học phần thay thế khoá luận
- 8 học phần đại cương
Phương pháp dạy và học
Tổng quan phương pháp
- Phát triển năng lực tự học hướng đến gia tăng cơ hội nghề nghiệp.
- Học thực hành thông qua các thiết bị y khoa hiện đại.
- Học tích hợp công nghệ thông minh trong phân tích dữ liệu y tế.
- Trải nghiệm thật cùng các chuyên gia đầu ngành tại các cơ sở y khoa.
Phương pháp học tập đa hình thức
- Mô phỏng và học qua tình huống lâm sàng giúp người học rèn luyện kỹ năng nghề nghiệp.
- Trải nghiệm quy trình thật tại các bệnh viện, trung tâm y tế và cơ sở xét nghiệm đa khoa chuyên sâu.
- Học trực tuyến thông qua nguồn dữ liệu lớn giúp học viên nâng cao năng lực phân tích.
- Học tăng cường với các chuyên gia trong việc xử lý các tình huống y tế khẩn cấp gắn với thực tiễn.
Năng lực đầu ra của chương trình
Sinh viên tốt nghiệp tự tin:
- Làm chủ lợi thế của ngành học trong chuỗi dịch vụ y tế và công nghệ sinh phẩm.
- Triển khai và điều phối quy trình xét nghiệm y học cùng đội ngũ y bác sĩ.
- Tham gia vào các dự án nghiên cứu về tế bào học, dịch tễ học, thiết bị chuyên khoa.
- Phát triển bản thân từ nền tảng y sinh và khả năng nghiên cứu, tiếp cận công nghệ.
Hệ sinh thái học tập
Innovation Center
Với campus hiện đại, Văn Lang hiện thực hóa mô hình Đại học Kiến tạo Đổi mới và Tác động, tận dụng công nghệ và sáng tạo để mở rộng cơ hội học tập suốt đời, khai phóng tiềm năng con người. Trường Đại học Văn Lang trao quyền cho mọi người học – không phân biệt xuất phát điểm – được tiếp cận giáo dục chất lượng cao, từ đó lan tỏa tri thức và giá trị tới cộng đồng.
Đội ngũ giảng viên
Khoa Kỹ thuật Y học - Trường Đại học Văn Lang quy tụ đội ngũ giảng viên giàu kinh nghiệm ở trình độ Thạc sĩ, Tiến sĩ và các chuyên gia trong ngành Khoa học Xét nghiệm Y tế. Các giảng viên không chỉ truyền đạt kiến thức cập nhật và các kỹ thuật xét nghiệm tiên tiến mà còn tận tâm bồi dưỡng kỹ năng nghề nghiệp và đạo đức y tế cho sinh viên. Nhờ đó, sinh viên được trang bị nền tảng vững chắc để tự tin làm việc tại các cơ sở y tế, bệnh viện và phòng thí nghiệm ngay sau khi tốt nghiệp.
Cồng đồng cựu sinh viên
Sinh viên đã tốt nghiệp
Sinh viên đang theo học
Có việc làm sau 1 năm tốt nghiệp
Triển vọng nghề nghiệp
Sinh viên được trang bị nền tảng chuyên môn vững chắc để tự tin phát triển sự nghiệp trong lĩnh vực y khoa:
- Kỹ thuật viên xét nghiệm y học
- Điều phối viên phòng xét nghiệm
- Chuyên viên xét nghiệm công nghệ cao
- Kỹ thuật viên đào tạo xét nghiệm y học
- Chuyên viên kiểm định và phân tích y sinh
- Quản lý phòng phân tích vi sinh
- Chuyên viên sàng lọc di truyền
- Nghiên cứu viên dự án y học
- Chuyên viên kỹ thuật y tế
Học phí & Học bổng
Học bổng tài năng Văn Lang
- 300 Suất học bổng Tinh hoa
- 100 suất học bổng Tài năng Toàn trường
- 400+ suất học bổng ngành
- 6.000 suất học bổng phát triển năng lực
Thông tin chính thức được công bố trên website của Trường Đại học Văn Lang trong tháng 03/2026.
Thông tin tuyển sinh
Năm 2026, bạn có thể đăng ký xét tuyển vào Trường Đại học Văn Lang theo 06 phương thức
- Kết quả thi đánh giá năng lực ĐHQG năm 2026;
- Kết quả thi đánh giá năng lực đầu vào đại học (V-SAT) năm 2026;
- Kết quả thi đánh giá tư duy trường ĐH Bách Khoa Hà Nội năm 2026;
- Điểm thi chứng chỉ quốc tế (SAT, IELTS, TOEFL iBT).
Xem thêm
- Học Kỹ thuật Xét nghiệm Y học tại Trường Đại học Văn Lang: Làm chủ hệ thống máy phân tích tự động và công nghệ y sinh hiện đại
- Ngành Kỹ thuật Xét nghiệm Y học tại Trường Đại học Văn Lang - Thực hành chuẩn bệnh viện, tư duy chuẩn quốc tế
- Học Kỹ thuật Xét nghiệm Y học không chỉ là lý thuyết: 70% thời lượng thực hành trực tiếp trên các mẫu phẩm thực tế
- Đặc quyền khi học ngành Kỹ thuật Xét nghiệm Y học: Tham gia các dự án nghiên cứu y sinh cùng đội ngũ chuyên gia đầu ngành
- Học Kỹ thuật Xét nghiệm Y học VLU: Đón đầu xu hướng "Chuyên gia Xét nghiệm 4.0
- Hệ sinh thái Kỹ thuật Xét nghiệm Y học chuẩn ISO: Nơi đào tạo cử nhân giỏi kỹ thuật, vững quy trình an toàn sinh học.
- Kỹ thuật Xét nghiệm Y học thời đại số: Ứng dụng AI trong phân tích hình ảnh tế bào và quản lý dữ liệu cận lâm sàng
- Dấu ấn Kỹ thuật Xét nghiệm Y học tại Trường Đại học Văn Lang: Lộ trình đào tạo bám sát nhu cầu bệnh viện
- Kỹ thuật Xét nghiệm Y học Trường Đại học Văn Lang: Lợi thế từ mạng lưới thực hành lâm sàng tại bệnh viện tuyến I
- Lộ trình học ngành Kỹ thuật Xét nghiệm Y học chuẩn quốc tế: Đảm bảo đầu ra IELTS 6.0 và khả năng thích ứng toàn cầu
Thông tin
Sự kiện trải nghiệm
Bạn muốn tham gia trải nghiệm nào tại Văn Lang?
Sự kiện trải nghiệm
Bạn muốn tham gia trải nghiệm nào tại Văn Lang?
Đăng ký tham gia Discovery Day VLU